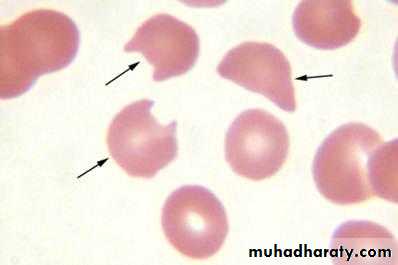
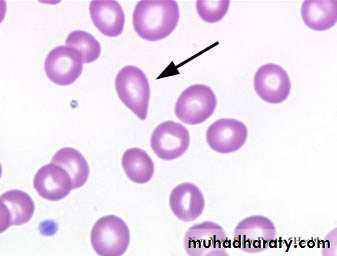

Bite cells , G6PD deficiency
Blister cells , G6PD deficiency
Howell jolly bodies
Hypersegmented neutrophil in mehaloblastic anemia
Fragmented RBC or schistocytes in MAHA
SICKLE CELL in sickle cell anemia
Spherocyte ( in heriditary spherocytosis & auto immune hemolytic anemia
Tear drop cells in myelofibrosis
Target cells in thalassemia & liver disease